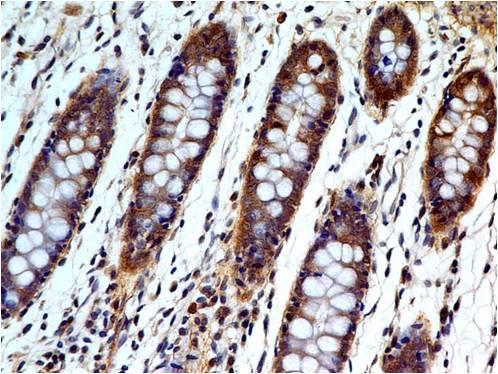

Monoclonal Antibody to Caspase-3 (Pro and Active) (Clone: ABM1C12)
Fig 1: Immunohistochemical analysis of Caspase-3 in human colon tissue using Caspase-3 antibody (Clone: ABM1C12) at 5 µg/ml.
Roll over image to zoom in
Shipping Info:
Order now and get it on Wednesday June 11, 2025
Same day delivery FREE on San Diego area orders placed by 1.00 PM
Format : | Purified |
Amount : | 100 µg |
Isotype : | Mouse IgG1 Kappa |
Purification : | Protein G Chromatography |
Content : | 25 µg in 50 µl/100 µg in 200 µl PBS containing 0.05% BSA and 0.05% sodium azide. Sodium azide is highly toxic. |
Storage condition : | Store the antibody at 4°C, stable for 6 months. For long-term storage, store at -20°C. Avoid repeated freeze and thaw cycles. |
Caspases are a member of the cysteine-aspartic acid protease family. Caspase-3 (31 kDa) is an executionary caspase which directly cleaves and activates poly(ADP-ribose) polymerase (PARP), sterol regulatory element binding proteins (SREBPs) or it can also interact with other caspases like caspase-6, -7 and -9. Increased levels of caspase-3 are involved in Huntington Disease-associated cell death. Caspase-3 is the principal caspase in mediating the cleavage of amyloid-beta 4A precursor protein (APP), which is related with neuronal death in Alzheimer's disease. Like other caspases, caspase-3 is also synthesized as a zymogen procaspase which is activated by specific proteolytic cleavage. High levels of caspase-3 are observed in lung, spleen, heart, liver and kidney, moderate levels in brain and skeletal muscle, and low in testis.
Western blot analysis: 2-4 µg/ml, Immunohistochemical analysis: 5-10 µg/ml, FACS analysis: 0.5-1 µg/10^6 cells
For Research Use Only. Not for use in diagnostic/therapeutics procedures.
Subcellular location: | Cytoplasm |
Post transnational modification: | S-nitrosylated on its catalytic site cysteine in unstimulated human cell lines and denitrosylated upon activation of the Fas apoptotic pathway, associated with an increase in intracellular caspase activity. Fas therefore activates caspase-3 not only by inducing the cleavage of the caspase zymogen to its active subunits, but also by stimulating the denitrosylation of its active site thiol. |
Tissue Specificity: | Highly expressed in lung, spleen, heart, liver and kidney. Moderate levels in brain and skeletal muscle, and low in testis. Also found in many cell lines, highest expression in cells of the immune system. |
BioGrid: | 107286. 102 interactions. |
There are currently no product reviews
|